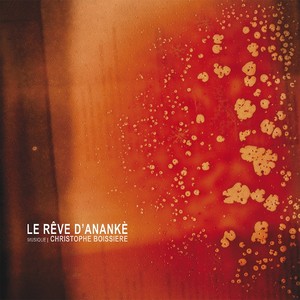
Anankè V

Otavio Moura
热门歌曲
-
David Arcaide、Oly Jr、Otavio Moura 3.41 MB 03:43
-
Otavio Moura 2.97 MB 03:14
-
Otavio Moura 2.6 MB 02:50
-
Otavio Moura 2.9 MB 03:10
-
Emmanuel Tugny、Christophe Boissière、Jacques El、Otavio Moura 3.42 MB 03:43
-
Emmanuel Tugny、Mina Samir、Jean-Baptiste Berger、Otavio Moura 2.63 MB 02:52
-
Emmanuel Tugny、Otavio Moura 2.5 MB 02:43
-
Emmanuel Tugny、Christophe Boissière、Suzanna Tissita、Otavio Moura 3.67 MB 04:00
-
Molypop、Emmanuel Tugny、Heine Wentz、Otavio Moura、Yann Linaar、Amauri Lablonovski 4.16 MB 04:32
-
Molypop、Emmanuel Tugny、Heine Wentz、Otavio Moura、Amauri Lablonovski 3.53 MB 03:51
-
Molypop、Emmanuel Tugny、Laure Limongi、Yann Linaar、Otavio Moura 2.81 MB 03:03
-
Molypop、Emmanuel Tugny、Christophe Boissière、Laure Limongi、Otavio Moura 1.67 MB 01:49
-
Molypop、Emmanuel Tugny、Yann Linaar、Otavio Moura、Alex Prinz 1.98 MB 02:09
-
Molypop、Emmanuel Tugny、Laure Limongi、Heine Wentz、Otavio Moura、Alex Prinz 2.27 MB 02:28
-
Molypop、Emmanuel Tugny、Yann Linaar、Otavio Moura、Alex Prinz 2.35 MB 02:34